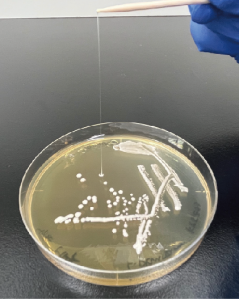

日本には古くから人々によって受け継がれてきた伝統的な漬物が日本各地に存在します。もともと漬物は野菜の保存食として利用するために作られたと考えられますが、保存技術が発達した現代においては、保存食としての役割よりも、食事に彩りを添えたり、箸休めの嗜好品としての役割に重きが置かれています。健康志向の高まりの影響もあって、多くの塩を加えてじっくり漬け込む伝統的な漬物よりも、浅漬けやキムチなどの塩分が低く、鮮やかな色味を楽しめる漬物のほうが、身近な存在になっています。このような社会の変化の中で、伝統的に作られてきたものが持つ、まだ明らかになっていない良さを見出していこう、というところからこの研究テーマは始まりました。
ぬか漬けたくあんの地域差
ぬか漬けの漬物は、商業的に作られているものもありますが、ご家庭にあるぬか床でぬか漬けを作っているという方も多いかと思います。発酵されたぬか床が市販されていたり、ぬか床を預けることができるお店があるなど、根強い人気があるぬか漬けの漬物ですが、研究テーマとしても実は古くから注目されています。ぬか床には様々な微生物がお互いに協力したり、牽制したりしながら、一つの共同体を作っていて、その製造環境が異なれば、当然その共同体の姿も変わってくると考えられます。このテーマでは地域で伝統的に作られている秋田のいぶりたくあんと愛知のあつみたくあんを題材として、その土地の風土に根付いた製法の違いと気候の違いが、ぬか漬け中の微生物群集にどのような影響を与えるかを調べました。秋田では寒冷な気候下で作られることもあり、微生物たちの力関係はお互い譲らず拮抗したままでしたが、愛知では温暖な気候が特定の微生物の生育を促進し、数種類の微生物の天下となっていました。できあがった漬物は秋田では素材の味が生かされており、愛知では乳酸発酵を生かした味になっていました。地域で受け継がれている製法が日本の食文化に多様性を与えていることを示す結果となりました。
この内容はScientific Reports誌に掲載されています。詳しくはこちら:[論文] [東工大ニュース] [ぐるなびニュースリリース]。また、多くの新聞媒体でこの研究を取り上げていただきました。詳しくはお知らせのページをご覧ください。
塩漬けの塩濃度の違いによる発酵菌叢の違いとその影響
「日本三大菜漬」と呼ばれる野沢菜漬、広島菜漬、高菜漬。これらの漬物の製造工程には塩で漬ける工程が共通してあります。しかし、その目的は異なっていて、広島菜漬や高菜漬では「塩蔵」と呼ばれる、高塩濃度で長期間漬け込む工程がある一方、一部の広島菜漬や野沢菜漬けは脱水を目的とした、低塩濃度で短期間漬け込む工程があります。野沢菜漬ではその後、再び低塩濃度で長期間漬け込み、乳酸発酵を利用する工程が続きます。この研究テーマでは、日本三大菜漬の製造工程の中で、複数の漬物で共有されている漬け込み条件に着目し、塩濃度の違いによって漬物製造に関わる微生物がどのように変わるのかについて明らかにしました。ぬか漬けたくあんでは地域の違いに着目しましたが、このテーマでは地域を越えて共有される仕組みに着目しています。その結果、高塩濃度で長期間漬け込んだ漬物では、特定のアミノ酸の含有量が上昇することがわかり、好塩性細菌の働きによってこの現象が起きているのではないかということが考えられました。
この内容はPeerJ誌に掲載されています。詳しくはこちら:[論文] [東工大ニュース] [ぐるなびニュースリリース]。
漬物の乳酸発酵時に起こる菌叢の経時変化とそのメカニズム
漬物研究は世界中に存在する漬物の数だけ行われてきたといってもいいほど、世界の研究者が取り組んでいるテーマの一つです。しかしながら、原料が違うことで発酵中の菌叢変化が変わってしまう上に、そもそも原料に由来する微生物も毎回異なってしまうため、菌叢変化の比較が非常に難しく、横断的なメカニズムの解明には至っていません。その困難を乗り越え、普遍的な漬物発酵におけるメカニズムを解明することを目的として、乳酸発酵を生かして作られている京都のしば漬けを題材として、研究を行いました。研究では「無菌なすジュース」を調製し、実際のしば漬の製造工程を調べて分かった菌叢を人工的に再構築し、実験室のコントロールした環境でその菌叢がどのように変化するか、そしてその変化が実際の製造時の菌叢変化とどう異なるかを調べました。この結果、実験室のコントロールした環境では最終的には乳酸桿菌のみになった一方、実際の製造時の菌叢は様々な微生物が共存する結果となっており、原料の違いによる環境の不均一さがこうした違いを生んでいるのではないかと推測されました。一方で、漬け込み初期にみられるグラム陰性菌や好気性菌の存在割合が低下していく様子は一致しており、まず好気性菌が消失し、次に酸感受性菌が消失する様子を実験データとして示しました。
この内容はMicrobiology Spectrum誌に掲載されています。詳しくはこちら:[論文] [東工大ニュース] [ぐるなびニュースリリース]。
漬物から単離した乳酸菌ライブラリ
免疫調整機能を持つ乳酸菌

漬物を洗った生理食塩水を培地に塗ると乳酸菌が生えてきます
地場野菜を使って漬物を作られている日本全国の漬物メーカー様からご提供いただいたサンプルから、乳酸菌を選び出し、乳酸菌ライブラリを作りました。これらの乳酸菌全てについてゲノム解析を行い、株ごとの特徴について検討をしています。また、その中から、細胞に働きかけ、免疫調整に重要な働きをする情報伝達物質を多く作り出させる乳酸菌を複数見つけました。
この内容は特許出願・登録しています。詳しくはこちら:[特許公報] [特許公報] [ぐるなびニュースリリース] [ぐるなびニュースリリース]。
発酵物に粘性を与える乳酸菌
曵糸性を持つLactiplantibacillus plantarum KY5-ES5株です
乳酸菌を探索している過程で、コロニーが糸を引く「曵糸性」を持つ株が見つかりました。この乳酸菌を乳酸菌用培地で培養すると、培養液がとろっと粘性を持つことがわかりました。このように発酵物に粘性を与える乳酸菌は、菌体外多糖(EPS)と呼ばれる物質を作り菌体や培地中のタンパク質の間に網目構造を作り、水分子が動きにくくなることで粘性を与えていると考えられています。こうした特徴を持つ乳酸菌は珍しいものではありませんが、この乳酸菌が作るEPSを調べたところ、多糖の構成分子にグリセロールが含まれていることがわかりました。菌体外に分泌する多糖でグリセロールを構成分子とするものは珍しく、他の菌体外多糖にはない機能や特徴を持つことが期待されます。
さらに豆乳を発酵させてみると、滑らかなテクスチャーをもつヨーグルトのような発酵物になりました。この「豆乳ヨーグルト」はそのまま食べるとさらっとした口溶けですが、かき混ぜるととろ〜りもっちりとした濃厚なテスクチャーに変わり、二つの食感が楽しめる発酵豆乳ができることがわかりました。

豆乳はなめらかなテクスチャーを示します
この豆乳ヨーグルトはこれまでに複数の展示会で紹介し、試食品を提供しています。試食された方々からは大変好評でした。こちらの乳酸菌を使った商品開発にご興味がありましたら、ぜひご連絡ください。
この乳酸菌 (Lactiplantibacillus plantarum KY5-ES5) は特許出願済です。[公開公報(国内)], [公表公報(PCT)]